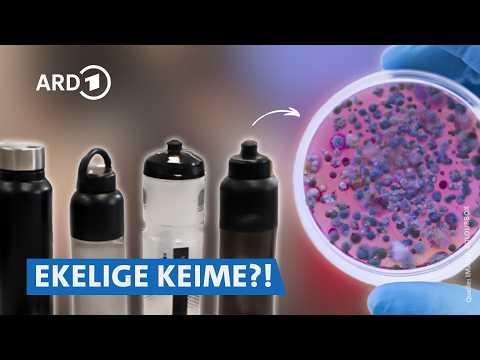
Lunchboxen & Trinkflaschen im Check: Glas, Edelstahl oder Plastik? 🍱 | Preiswert, nützlich, gut? SWR

About 106 results for "UCxec_VgCE-5DUZ8MocKbEdg"
Featured Results

PT1M9S
Sklaverei auf Kaffeeplantagen? Starbucks verklagt ☕| Eine Minute Geld MDR #Shorts
ARD MarktcheckDec 8, 2025
PT8M17S
Winterreifen günstig kaufen über Check24 – Praxistest & Erfahrungen | Markt WDR
ARD MarktcheckDec 7, 2025
PT48S
Warum Butter jetzt plötzlich so billig ist | Eine Minute Geld MDR #Shorts
ARD MarktcheckDec 6, 2025
PT57S
Italien will dem ICE den Kampf ansagen! 🤌 | Eine Minute Geld MDR #Shorts
ARD MarktcheckDec 5, 2025
PT13M32S
Smart Home: Das bringen MIR vernetzte Geräte wirklich! | FYI – unsere Recherche, Dein Vorteil rbb
ARD MarktcheckDec 5, 2025
PT15M49S
Free2Play: Warum du plötzlich doch zahlst - die Maschen der Gaming-Industrie | BUY BETTER SWR
ARD MarktcheckDec 4, 2025
PT1M10S
Sie schnappt den Hacker, der sie abzocken wollte! 💪 | Echt? WDR #shorts
ARD MarktcheckDec 3, 2025
PT8M39S
XXL-Angebote entlarvt: Warum Großpackungen häufig keinen Vorteil bieten | Marktcheck SWR
ARD MarktcheckDec 1, 2025
PT50S
Vergessene Kohle auf deutschen Konten 💰❓ | Eine Minute Geld MDR #Shorts
ARD MarktcheckDec 1, 2025
PT13M22S
DARUM zahlen wir so viel für Dyson - lohnt es sich? | BUY BETTER SWR
ARD MarktcheckNov 27, 2025
Fisch & Meeresfrüchte: Das solltest du über Lachs, Scampi & Co. wissen! 🐟🍤| Die Tricks... NDR
ARD MarktcheckNov 19, 2025
Marke vs. No-Name-Produkte – was ist besser? Die Wahrheit über Eigenmarken | Doku & Reportage SWR
ARD MarktcheckNov 19, 2025
PT44M11S
Siegel und Labels: Wie streng wird wirklich geprüft? | Die Tricks...NDR
ARD MarktcheckNov 17, 2025
PT23M26S
Dividenden: Kluge Strategie oder überschätzter Finanz-Mythos? 🤔 I 50k HR
ARD MarktcheckOct 15, 2025
PT29M29S
White Snus: Wie die Tabakindustrie EUCH mit neuen Produkten süchtig macht | Echt? WDR
ARD MarktcheckOct 10, 2025
PT13M6S
DAS brauchst du wirklich zum Laufen mit @Danny_Run & @savagesavas1658 | BUY BETTER SWR
ARD MarktcheckOct 9, 2025
PT43M48S
Airfryer, Pyrolyse, Dampfgaren – Welche Backofen-Funktionen lohnen sich? I Der Haushalts-Check WDR
ARD MarktcheckSep 26, 2025
Undercover-Recherche: So arbeiten Paketzusteller bei DPD 📦| Voss & Team MDR
ARD MarktcheckSep 19, 2025
PT8M40S
Tiefkühl-Pizza im Vergleich: Wie gut ist Premium wirklich? 🍕 | Markt WDR
ARD MarktcheckSep 14, 2025
PT22M34S
SO erstellst du das perfekte Depot für deine Altersvorsorge! | 50k HR
ARD MarktcheckSep 3, 2025
PT44M31S
Action: Wie gut ist der Discounter-Riese wirklich?🔎 | Marktcheck checkt… SWR
ARD MarktcheckAug 25, 2025
Ordnung halten auf kleinem Raum: Die besten Systeme | Preiswert, nützlich, gut? SWR
ARD MarktcheckAug 19, 2025
PT44M45S
Wie gut ist Engelbert Strauss? Qualität, Preise & Nachhaltigkeit | Marktcheck checkt… SWR
ARD MarktcheckAug 12, 2025
PT14M44S
AutoScout24, mobile.de & WKDA: DAS bekommst du wirklich! | BUY BETTER SWR
ARD MarktcheckJul 31, 2025
PT44M42S
Diese Eismaschinen lohnen sich – und diese nicht 🍨 | Preiswert, nützlich, gut? SWR
ARD MarktcheckJul 20, 2025
Fake Rolex? How good are counterfeit luxury watches really? ⌚🤔 | Real? WDR
ARD MarktcheckJul 19, 2025
PT13M34S
Lohnen sich Mystery Boxen von eBay, MediaMarkt & Co.? | FYI – unsere Recherche, Dein Vorteil NDR
ARD MarktcheckMay 21, 2025
PT44M38S
Thermomix TM6 & TM7 vs. Xiaomi und SilverCrest: Der große Check 🥇 | Der Haushalts-Check WDR
ARD MarktcheckApr 25, 2025
PT44M42S
SO werden wir beim Einkaufen getäuscht – fiese Tricks mit Lebensmitteln 2025 | Die Tricks NDR
ARD MarktcheckApr 14, 2025
Blitzer-Apps & Gadgets: Das MÜSST ihr wissen! 🚨| FYI – unsere Recherche, Dein Vorteil NDR
ARD MarktcheckMar 19, 2025Swipe to view more pages